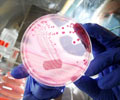
Marburg Virus Disease - Causes, Symptoms, Diagnosis, Treatment, Prevention

Rwanda confirms six deaths and 20 cases of Marburg disease, with the majority of victims being healthcare workers.

‘Did you know?
88% of people affected by the Marburg virus may not survive. #marburg_virus #fever #rwanda #medindia’





88% of people affected by the Marburg virus may not survive. #marburg_virus #fever #rwanda #medindia’
What is Marburg Disease?
Marburg disease is a viral hemorrhagic fever that can cause death among some patients. Symptoms include severe headache, vomiting, muscle aches, and stomach aches. The disease has a fatality rate as high as 88%.Institutions and partners are working to trace those who have been in contact with virus-affected individuals, the minister added. Marburg is from the same virus family as Ebola and is transmitted to people from fruit bats. It then spreads through contact with the bodily fluids of infected people.
Risks and Effects of the Marburg Virus
The fatality rate of this disease can reach up to 88%, making it extremely dangerous. Transmission typically occurs from fruit bats to humans, and once infected, it can spread through contact with bodily fluids.The Rwandan government, along with international health organizations, is actively working to contain the outbreak. Measures include isolating infected individuals, tracing contacts, and providing necessary medical care to those affected.
Advertisement